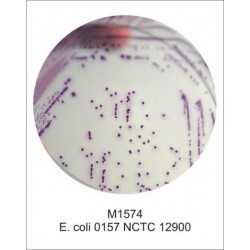
HiCrome™ EC O157 : H7 Agar (equivalent to M1298), 500g
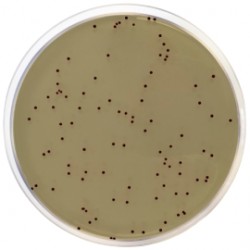
KF Streptococcal Agar , 500 G

Search Criteria
Products meeting the search criteria
Brand: SISCO
Model: SISCO
Product Details Hektoen Enteric AgarConcentration 75.66 gm/lit.
Part D
Storage : 8 to 25°C (Cool & dry area)
Shelf Life : 36 Months
HSN Code : 38210000
IMDG Identification :Not Regulated for Transport (Non-Haz)Specifications
Used for the isolation and cultivation of gram negativ..
605.13 SAR
Ex Tax:526.20 SAR
Model: ARK1565970
..
10.00 SAR
Ex Tax:10.00 SAR..
6,727.50 SAR
Ex Tax:5,850.00 SAR
Brand: Neogen
Model: Neogen
Product OverviewIron Sulphite Agar is a medium for the detection of thermophilic anaerobic organisms causing sulphide spoilage in food, and is not intended for use in the diagnosis of disease or other conditions in humans.This formulation is a modification of Cameron Sulphite Agar, which wa..
1,071.00 SAR 1,071.00 SAR
Ex Tax:1,071.00 SAR
Brand: SISCO
Model: SISCO
Product Overview33943Kligler Iron Agar
Concentration 57.52 gm/lit.
Part D
Storage: 8 to 25°C (Cool & dry area)
HSN Code: 38210000
IMDG Identification: Not Regulated for Transport (Non-Haz) Directions :1. Add 57.52 gm powder to distilled/deionized ..
223.10 SAR
Ex Tax:194.00 SAR
Brand: HiMedia
Product Overview
MU022
Levine Eosin - Methylene Blue Agar Mediumfor isolation, enumeration and differentiation of members of Enterobacteriaceae in accordance with USP.Package: 500 G..
289.80 SAR
Ex Tax:252.00 SAR
Brand: HiMedia
Product Overview
MU022
Levine Eosin - Methylene Blue Agar Mediumfor isolation, enumeration and differentiation of members of Enterobacteriaceae in accordance with USP.Package: 500 G..
289.80 SAR
Ex Tax:252.00 SAR
Brand: HiMedia
Model: M1064-500G
Product OverviewM1064
Listeria Identification Agar Base (PALCAM)
(Complies as per ISO 17025:2005)for selective isolation and identification of Listeria species.
Package Size: 500 G..
771.65 SAR
Ex Tax:671.00 SAR
Brand: SISCO
Product OverviewListeria Oxford Medium Base (Oxford Agar)
Concentration 55.6 gm/lit.
Part D
Storage: 8 to 25°C (Cool & dry area)
HSN Code: 38210000
IMDG Identification:Not Regulated for Transport (Non-Haz)Package Size: 500 G..
531.30 SAR 531.30 SAR
Ex Tax:462.00 SAR
Brand: SISCO
Model: SISCO
Product OverviewLuria Bertani Agar, Lennox
(Luria Agar)(LB Agar Lennox)46502Concentration 35.00 gm/lit.
Part D
Storage: 8 to 25°C (Cool & dry area)
Shelf Life: 36 Months
HSN Code: 38210000
IMDG Identification: Not Regulated for Transport (Non-Haz)Package Size: 500 G..
437.00 SAR
Ex Tax:380.00 SAR